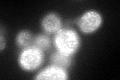
YDR032C
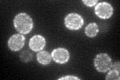
YDR032C

View description
Protein with similarity to members of a family of flavodoxin-like proteins; induced by oxidative stress in a Yap1p dependent manner; the authentic, non-tagged protein is detected in highly purified mitochondria in high-throughput studies
Localization:
Intensity:
Fold change:
Significance:
-
C’ GFP library in SD

punctate54.4 -
N' NOP1pr-GFP in SD

cell periphery427.099 -
N' TEF2pr-mCherry in SD

cell periphery79.738 -
N' NATIVEpr-GFP in SD

cell periphery,punctate90.0925 -
N' TEF2pr-VC and Cyto-VN in SD

cell periphery,punctate71.2793 -
C’ GFP library in SD+DTT
punctate67.681.24No -
C’ GFP library in SD+H2O2

punctate61.071.12No -
C’ GFP library in Starvation Media
punctate122.62.25Yes -
C’ GFP library on the background of Pup2-DaMP

punctate -
C’ GFP library on the background of CCT mutant

punctate54.13590.995061No
